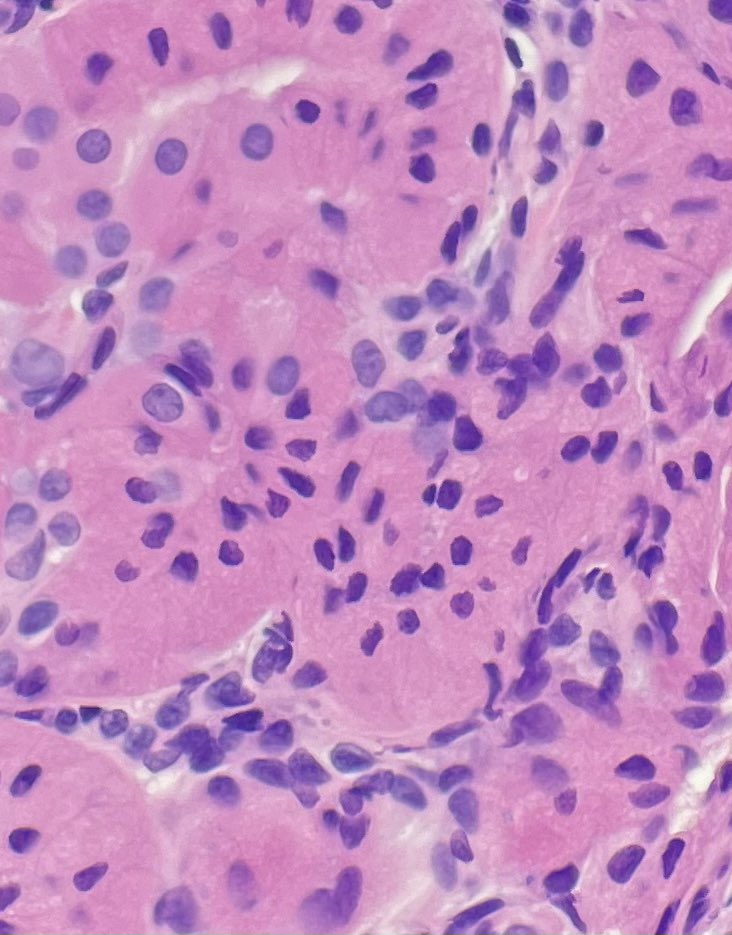
73 YOF conjunctival nodule (*classic presentation- elderly female*) there are some juicy mitochondria down there  <a href="/ingridtam/">Ingrid Tam</a> @thedermypathres <a href="/KaranKVats/">Karan Vats</a>  <a href="/josuelilly/">Josué Lilly</a> 👀 👀 #dermpath #dermtwitter #opthopath #ENTpath #PathTwitter #pathresidents
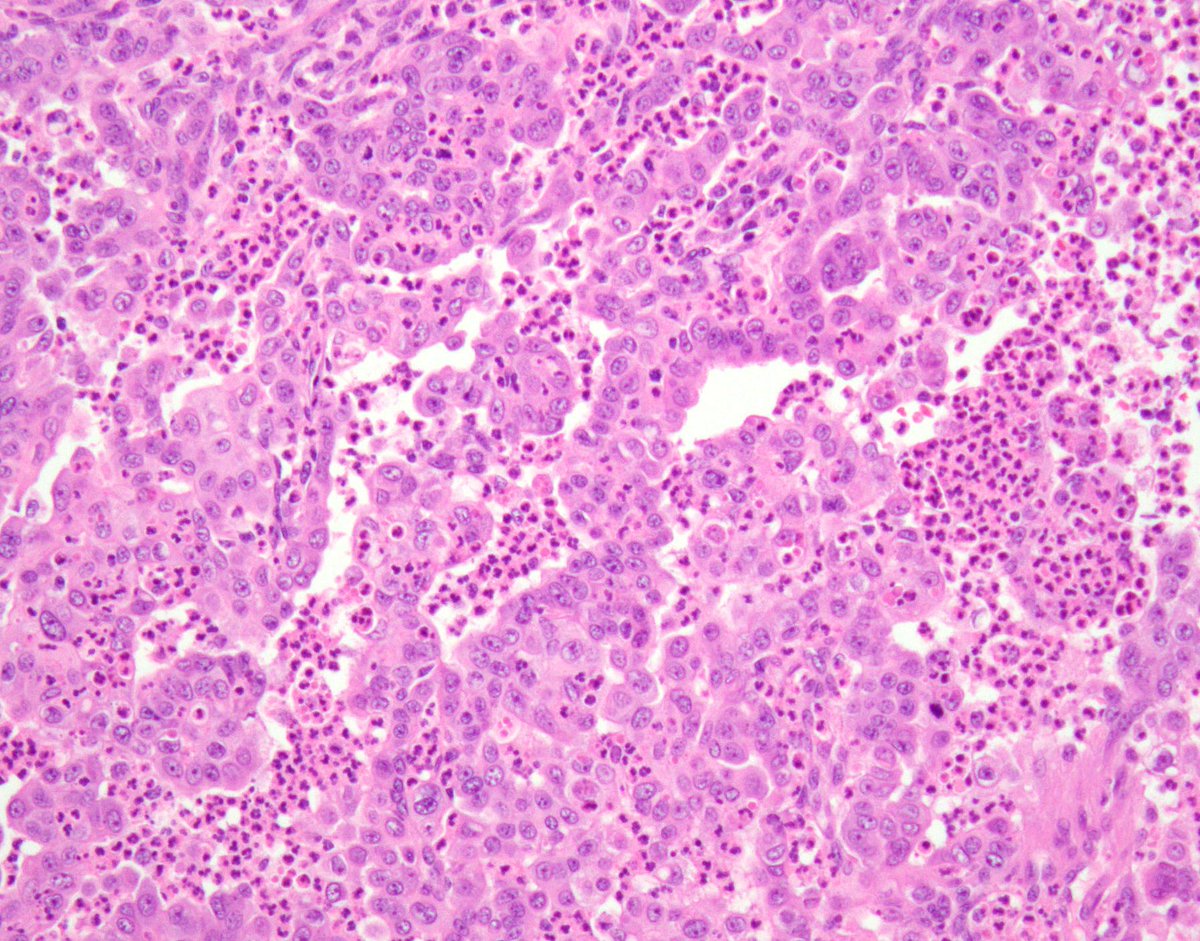
Renal Medullary Carcinoma 1/

Classic Associations:
- Adolescent / young adult w/ Sickle Cell Trait
- Highly infiltrative w/fibromyxoid &amp; desmoplastic stroma 
- Necrosis &amp; 'micro-abscesses'

Clinically, aggressive w/poor outcomes

#gupath #kidneycancer #KidneyCancerAwarenessMonth
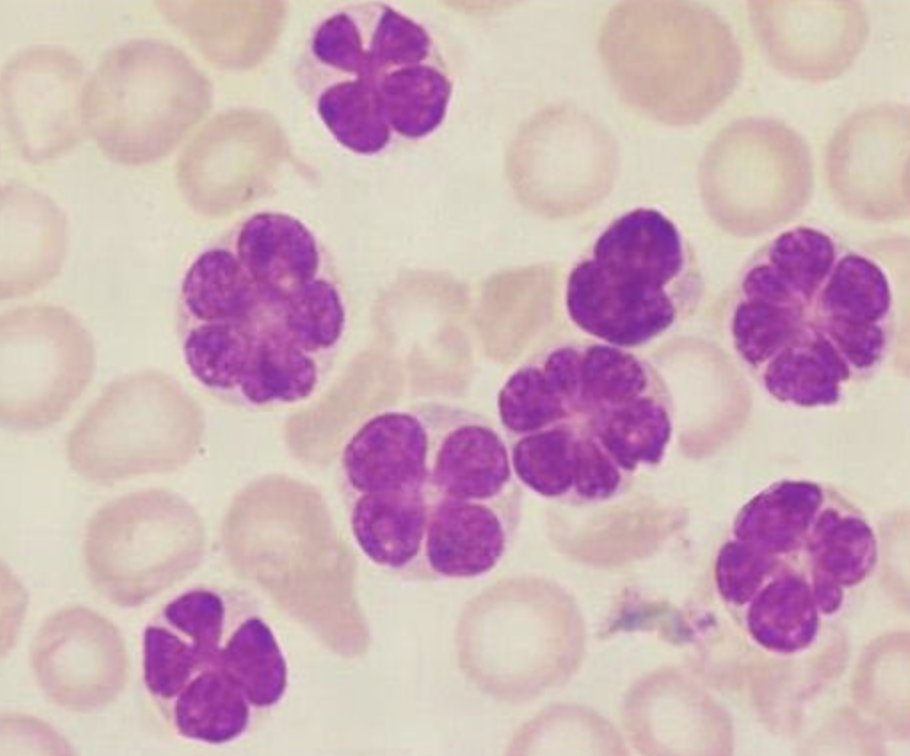
#idboardreview 50 Japanese male w/ 1 month of fatigue, generalized lymphadenopathy, wbc 90k w/60% of circulating atypical lymphocytes along with flower cells (lobulated nuclear configuration). dx? #medEd #idmeded #idtwitter

Ingrid Tam
@ingridtam
foodie, explorer, pathologist-in-training @usask
ID: 72338355
07-09-2009 17:48:51
28 Tweet
41 Followers
164 Following









#pathsketch #pathodoodle showing some of the atypical lymphocytes and their morphological differentials🔎🔬💉. #pathboards #morphology #hematology #hemepath Archana bhat Anju Pandey Umashankar Lovely george, MD, PDCC Blood Research & Hematologic Diseases Pathodoodles by Deeksha Sikri



The Parasite Case of the Week 632 is up: a fun histopath case with a twist: parasitewonders.blogspot.com/2021/03/case-o… #asmclinmicro #MayoClinMicro #mayopath #parasites #path2path #pathology Jerad Gardner, MD Mayo Clinic Labs ASTMH CAPathologists ASP-Parasitologists London School of Hygiene & Tropical Medicine





A teenage female with hematuria and a 3.7 cm bladder mass on CT scan underwent transurethral resection. Contributors: Ingrid Tam, Nick Baniak The GU Pathology Society (GUPS) Case of the Week: gupathsociety.org/COW-2021-24 Send your cases to Francesca Khani, MD @akgulMD #GUPSCOW #GUpath #pathology




73 YOF conjunctival nodule (*classic presentation- elderly female*) there are some juicy mitochondria down there Ingrid Tam @thedermypathres Karan Vats Josué Lilly 👀 👀 #dermpath #dermtwitter #opthopath #ENTpath #PathTwitter #pathresidents